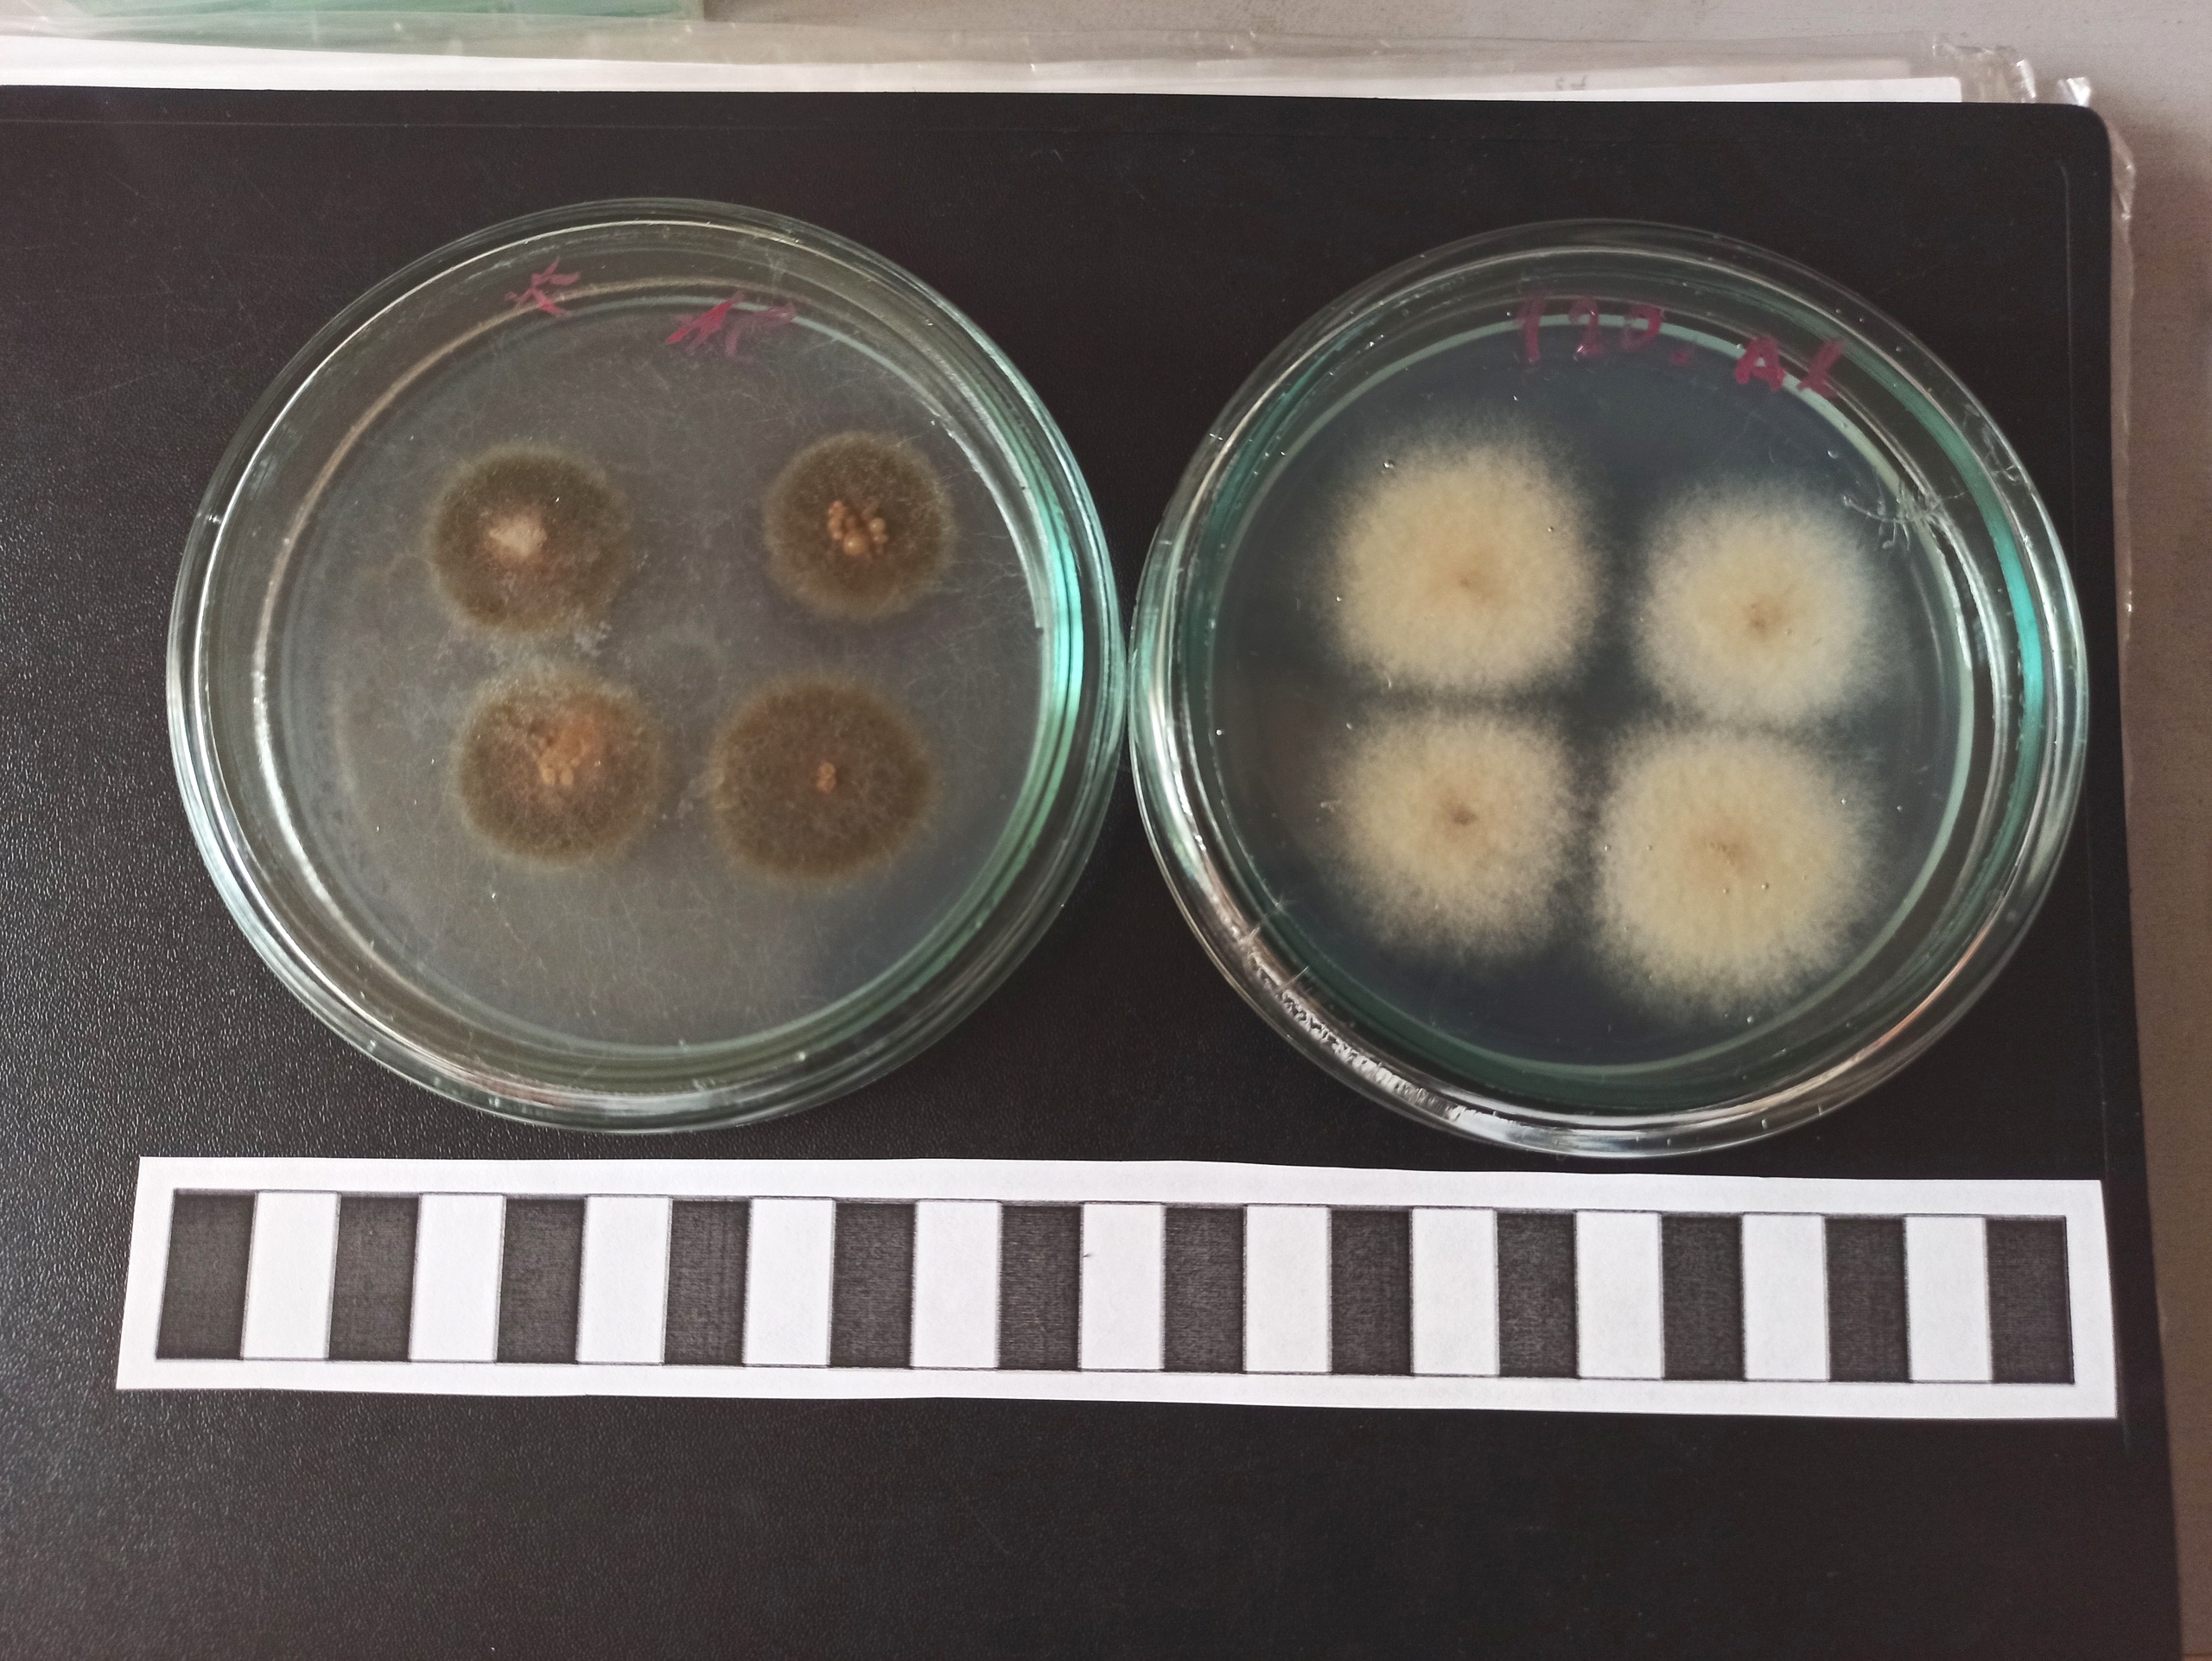
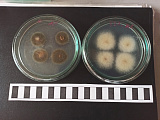

Молодой биолог ЧелГУ ищет экологически безопасные способы улучшения качества зерна
Выпускник бакалавриата биологического факультета Челябинского государственного университета Михаил Клюшник под руководством доцента кафедры микробиологии, иммунологии и общей биологии ЧелГУ Татьяны Головиной оценил влияние электромагнитного излучения и коронного разряда на грибную микрофлору зерна пшеницы с чёрным зародышем. Научный дебют получил лестные отзывы экспертов.

Выпускник бакалавриата биологического факультета Челябинского государственного университета Михаил Клюшник под руководством доцента кафедры микробиологии, иммунологии и общей биологии ЧелГУ Татьяны Головиной оценил влияние электромагнитного излучения и коронного разряда на грибную микрофлору зерна пшеницы с чёрным зародышем. Научный дебют получил лестные отзывы экспертов.
Физические воздействия, как пояснил автор работы, заслуживают внимания, прежде всего потому, что они оказывают негативное влияние на патогенную микрофлору зерна. В результате благотворных изменений происходит стимуляция ростовых показателей зерна пшеницы. Немаловажен и тот факт, что электромагнитное воздействие и коронный разряд – экологически чистые методы, в отличие от химических аналогов.
«Инфекции грибной этиологии очень сложно уничтожить полностью, – отмечает Михаил Клюшник. – Поэтому наша задача была не устранить, а ослабить развитие инфекции и стимулировать прорастание зерна, чтобы получить больше сильных проростков. Зёрна пшеницы с чёрным зародышем называют так из-за их облика и локализации мицелия грибов. Зерно с чёрным зародышем ослаблено, прорастает медленно, растение становится уязвимым для других болезней. Возбудители – микромицеты Alternaria alternata и Bipolaris sorokiniana, которые производят опасные для человека и сельскохозяйственных животных микотоксины».
Изыскания в этом русле уже велись в ЧелГУ: группа учёных в составе которой были профессор кафедры радиофизики и электроники Игорь Бычков, доцент кафедры радиофизики и электроники Илья Зотов и доцент микробиологии, иммунологии и общей биологии Татьяна Головина, ранее изучали влияние электромагнитного излучения СВЧ-диапазона на культуру грибов рода Alternaria.
Физическое воздействие на зародыш зерна интересует научные умы и в других регионах России. Так, грибы рода Alternaria интенсивно изучаются в Санкт-Петербурге, в лаборатории микологии и фитопатологии Всероссийского научно-исследовательского института защиты растений под руководством Филиппа Ганнибала. Исследовали влияние ультрафиолетового излучения и излучения плазмы импульсного искрового разряда на зерно пшеницы и мицелий микромицетов-деструкторов и в Нижегородском университете им. Н. И. Лобачевского. Влияние физических факторов на патогенную микрофлору сельскохозяйственной продукции исследуют в Красноярском ГАУ и в ряде других отечественных вузах.
«Тема заинтересовала меня прежде всего из-за усиления тенденции поражения пшеницы грибами, вызывающими заболевание «чёрный зародыш» и связанное с этим снижение товарных качеств зерна и стойкости при хранении, – отмечает Михаил Клюшник. – Меня всерьёз увлёк процесс поиска рациональных и экологически чистых технологий для борьбы с грибной полевой инфекцией. Обеззараживание физическими методами – это действительно перспективное и безопасное решение».
Говоря о сложностях в процессе исследования, начинающий учёный выделяет этап сборки действующей установки для обработки коронным разрядом, которая собиралась с нуля и полностью своими силами. А вот приборы для обработки инфракрасным и ультрафиолетовым излучением были предоставлены исследователю кафедрой радиофизики и электроники физического факультета ЧелГУ.
«Практическая часть работы начиналась с отбора зерна пшеницы с чёрным зародышем из партий, изъятых из зернохранилищ юга Челябинской области, – рассказывает Михаил Клюшник. – Затем проводилась обработка материала электромагнитным излучением и коронным разрядом в соответствующих режимах. По гостированным методикам фиксировалась всхожесть, замерялась длина ростка, определялась сила роста зерна. Для изучения влияния физического воздействия на рост и размножение микромицетов родов Alternaria и Bipolaris был произведен их пересев с зерна на агар Чапека с выделением чистых культур и дальнейшим инкубированием, с соблюдением оптимальных для роста грибов условий. Для обнаружения эффекта от физического воздействия исследовались морфометрические показатели размеров и формы конидий Alternaria и Bipolaris с проведением анализа микрофотографий спороношения, наблюдаемого у исследуемых грибов после различных режимов физического воздействия в программе ImageJ».
В ходе исследования учёный производил замер диаметра выращенных на питательной среде колоний грибов, рассчитывая радиальную и удельную скорость их роста. По результатам наблюдений и проделанных расчётов были рекомендованы режимы обработки зерна коронным разрядом, при которых снижается активность патогенных грибов и оказывается стимулирующий эффект на рост зерна пшеницы.
Исследования в заданном направлении будут продолжены в ЧелГУ. Сегодня в сельском хозяйстве делаются попытки применения электромагнитного излучения и коронного разряда, но они требуют совершенствования и поиска новых эффективных режимов.